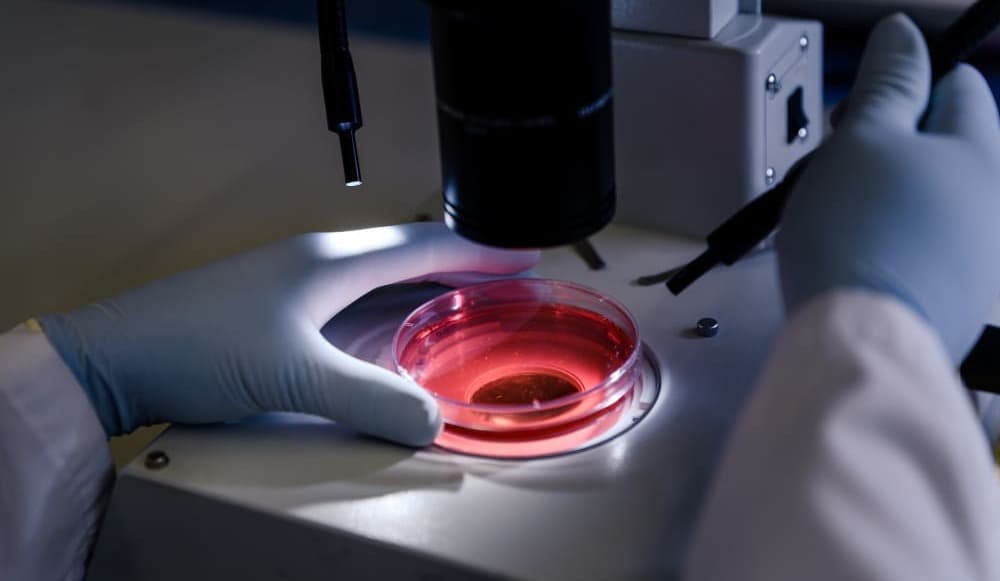
главное фото

24 июля 2025
%20(1).jpg&w=1920&q=75)
Американские исследователи впервые устранили мутацию, вызывающую синдром мультисистемной дисфункции гладкой мускулатуры на доклиническом этапе.
Учёные из Юго-Западного медицинского центра Техасского университета добились успеха в лабораторной коррекции генной мутации, вызывающей крайне редкое и опасное заболевание гладкой мускулатуры — синдром MSMDS. Новый подход вернул клеткам способность нормально функционировать и стал первым шагом к потенциальной терапии, способной изменить жизнь пациентов. Результаты исследования опубликованы в журнале Circulation.
Синдром мультисистемной дисфункции гладкой мускулатуры (MSMDS) — крайне редкое наследственное заболевание, вызванное мутацией в гене ACTA2, кодирующем альфа-актин — белок, обеспечивающий сокращение гладкой мускулатуры.
Поскольку гладкие мышцы присутствуют в стенках кровеносных сосудов и внутренних органов, болезнь затрагивает несколько систем организма: дыхательную, мочевыделительную, пищеварительную и зрительную. Симптомы включают затруднённое дыхание, расстройства ЖКТ, нарушение мочеиспускания, а также офтальмологические проблемы. Особенно опасны сосудистые осложнения — аневризмы и диссекции аорты. MSMDS диагностируется редко, а прогрессирующее течение болезни требует постоянного наблюдения и междисциплинарного подхода в лечении.
В поисках лечения этого редкого заболевания американские генетики провели доклиническое исследование, в ходе которого с помощью современных технологий редактирования ДНК им удалось исправить мутацию в гене ACTA2 — ключевой причине развития синдрома мультисистемной дисфункции гладкой мускулатуры.
Исправленный ген позволил клеткам гладкой мускулатуры вновь сокращаться в нормальном режиме и утратил патологическую склонность к чрезмерному размножению — одному из основных факторов поражения сосудов и внутренних органов у пациентов с MSMDS.
На сегодняшний день пациенты с MSMDS живут под постоянным медицинским наблюдением и нуждаются в симптоматической терапии, но эффективного этиотропного лечения до сих пор не существовало. Новый метод генной коррекции может стать основой будущей терапии, направленной на устранение первопричины заболевания.
ООО «ЭМГ» г. Москва, ул. Народная, д. 14, стр. 3
ОГРН 5087746488440
© Помощь редким, 2026
Напишите нам
Info@rare-aid.com